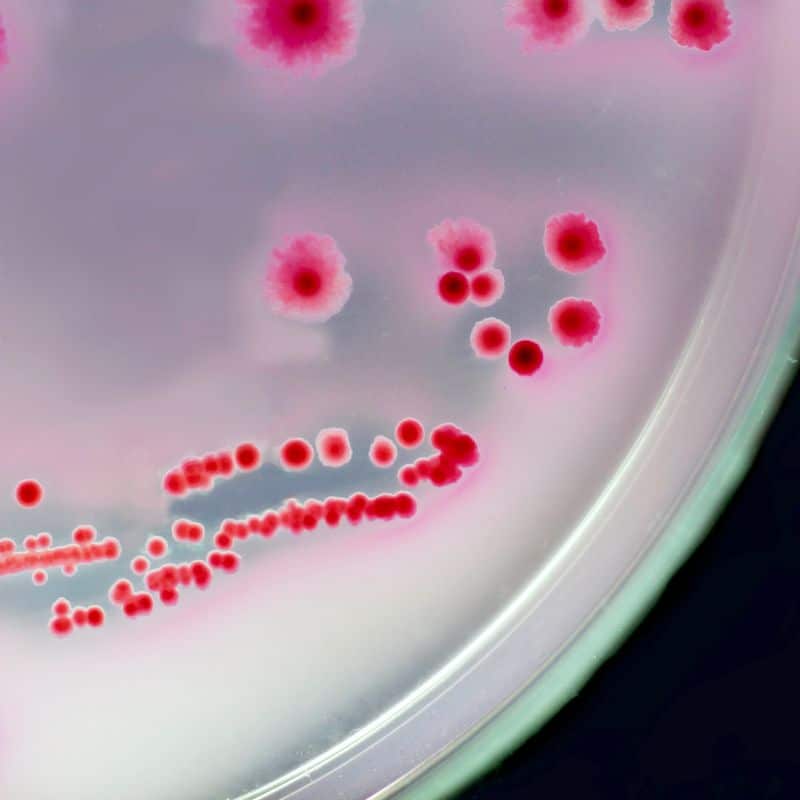
Microbiota vaginal: ¿qué es?

¿Qué es la microbiota vaginal?
Las bacterias son seres vivos microscópicos que habitan prácticamente todos los ecosistemas de la Tierra. Sin ellas, la vida sería imposible, ya que reciclan desechos, transforman la materia, son el sustrato alimenticio de muchísimos seres vivos y posibilitan los ciclos biogeoquímicos de los ecosistemas. Además de todo esto, las bacterias también colonizan la superficie y el interior de los seres vivos, incluido el ser humano. ¿Quieres conocerlo todo sobre la microbiota vaginal?
Aunque la microbiota intestinal o flora intestinal sea la que más protagonismo se lleva cuando hablamos de comunidades microbianas en el interior del cuerpo humano, no hay que olvidar que las bacterias colonizan otros muchos tejidos, incluyendo piel, ojos, vagina y más. Aquí te lo contamos todo sobre la microbiota vaginal, incluyendo los posibles efectos secundarios de su desequilibrio.

Estudio de Microbiota Avanzada
Conoce tu microbioma y potenciales disbiosis.
449€ - 399€
Microbiota vaginal: definición y términos
El término microbiota se emplea para describir al conjunto de microorganismos que se encuentran en los seres multicelulares, en este caso el ser humano. Aunque en la mayoría de los casos este concepto se asocie a comunidades bacterianas, también se incluyen en él arqueas, protistas, hongos y virus. La mayoría de los integrantes de la microbiota son o simbiontes (realizan una labor para el hospedador) o comensales, es decir, que no hacen ni bien ni mal. También hay un número reducido de ellos que pueden llegar a ser patógenos.
La microbiota incluye a las especies, géneros y filos que habitan en un entorno concreto. Por otro lado, el microbioma tiene en cuenta al número de integrantes, pero también sus relaciones, productos metabólicos, condiciones ambientales, material genético libre, interacciones avanzadas y más. Dicho de otro modo, el microbioma es la extensión funcional de la microbiota. Con fines divulgativos vamos a utilizar el término microbiota, pero suele ser más correcto emplear la designación de microbioma.
Con estas definiciones en mano, es fácil llegar a la conclusión de que la microbiota vaginal es el conjunto de microorganismos que colonizan la vagina, el conducto elástico que forma parte del aparato reproductor femenino. Este entorno puede experimentar varios cambios debido a procesos naturales, como la menstruación, las relaciones sexuales o el embarazo. Si las variaciones en la microbiota son significativas y causan síntomas, se puede hablar de un cuadro clínico conocido como disbiosis vaginal.
Composición general de la microbiota vaginal
Las principales bacterias colonizadoras de la microbiota vaginal pertenecen al género Lactobacillus. Estos se consideran los “guardianes” del ecosistema de la vagina, ya que se ha demostrado su capacidad para inhibir de forma directa el crecimiento de organismos patógenos. Tal y como indican estudios, más del 70% de la muestra de un exudado vaginal está compuesta por lactobacilos. Sin duda, son el grupo microscópico más representativo de este entorno.
La microbiota vaginal o flora vaginal se puede resumir en los siguientes grupos:
- Cocos y bacilos (Gram positivos y anaerobios aerotolerantes/ facultativos): Lactobacillus y Streptococcus. Corynebacterium, Gardnerella y Staphylococcus.
- Micoplasmas: géneros Mycoplasma y Ureaplasma.
- Bacilos (Gram negativos anaerobios facultativos): Proteus, Klebsiella y Escherichia.
- Bacilos y cocos (Gram positivos anaerobios estrictos): Atopobium, Peptococcus, Clostridium, Bifidobacterium y más.
- Bacilos (Gram negativos y anaerobios estrictos): Bacteroides y Prevotella.
Muchas de las bacterias anaerobias estrictas citadas dominan el tracto gastrointestinal. Estas aparecen en la vagina de forma más o menos esporádica, por lo que se considera que son pasajeras y no forman una comunidad estable dentro de este entorno. Por otro lado, aunque se conozcan más de 140 especies pertenecientes al género Lactobacillus, las que dominan el entorno vaginal son L. crispatus, Lactobacillus gasseri, Lactobacillus jensenii y L. iners.
Funciones de la microbiota vaginal
Los lactobacilos son los microorganismos más prevalentes en este entorno y, por tanto, esenciales para su correcto funcionamiento. Algunas de sus funciones más importantes son las siguientes:
- Producción de compuestos antimicrobianos: la síntesis de peróxido de hidrógeno (H2O2) es un mecanismo bien conocido para el antagonismo bacteriano, ya que inhibe el crecimiento de microorganismos patógenos mediante interacción directa. Los lactobacilos que producen estos compuestos pueden inactivar virus y bacterias directamente.
- Estabilización del pH: los bacilos producen ácido láctico, lo cual se traduce en una acidificación del entorno. El pH vaginal es de aproximadamente 4, inhibiendo así el crecimiento de muchísimos microorganismos patógenos.
- Síntesis de agentes tensoactivos: L. acidophilus y L. fermentum producen agentes tensoactivos que podrían inhibir la adhesión de ciertos patógenos al epitelio vaginal.
- Formación de una biopelícula protectora: la adhesión de la microbiota vaginal a sus paredes permite que se forme una biopelícula protectora. Esta actúa como barrera física frente a la adhesión de microorganismos nocivos.
Como puedes comprobar, la microbiota vaginal protege este entorno de forma tanto directa como indirecta. Su finalidad es evitar la instauración de otros microorganismos para proteger su ecosistema y, por tanto, a su hospedador (la mujer).
Disbiosis vaginal
Si los microorganismos “buenos” de la microbiota vaginal se reducen en número y representación por cualquier motivo (estrés, embarazo, terapia de reemplazo hormonal, uso de antibióticos y otros), es posible que los patógenos oportunistas ocupen su lugar y comiencen a proliferar de forma descontrolada. Esto causa una disbiosis vaginal, que deriva en los siguientes síntomas:
- Inflamación de la mucosa vaginal.
- Picor vaginal.
- Sensación de ardor intenso al orinar (disuria).
- Secreciones vaginales anormales, con aspecto similar al requesón (blancas y grumosas).
- Lesiones cutáneas en las zonas más comprometidas.
Dependiendo del agente causal, pueden ser necesarios antibióticos, antimicóticos u otros medicamentos. Además, lo ideal es encontrar el motivo por el cual se ha producido el desbalance para evitar que ocurra en futuras ocasiones.
La microbiota vaginal cumple una serie de funciones esenciales para el bienestar genital femenino. Es importantísimo mantenerla sana para evitar infecciones por patógenos oportunistas a corto y largo plazo. Si tienes cualquier duda con respecto a este tema, no dudes en consultar con un profesional en ginecología.
-
Test de Aliento – SIBO
75,00 €El precio original era: 75,00 €.67,00 €El precio actual es: 67,00 €. Comprar -
Estudio Avanzado de Microbiota y Disbiosis
449,00 €El precio original era: 449,00 €.399,00 €El precio actual es: 399,00 €. Comprar





